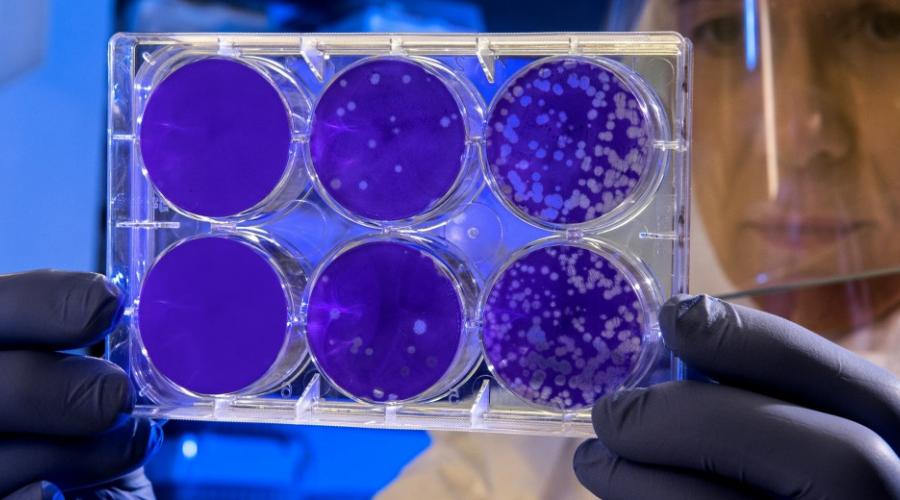

Ποιοι δρόμοι θα είναι κλειστοί στο κέντρο της Αθήνας στις 2/10 και γιατί
Κυκλοφοριακές ρυθμίσεις θα πραγματοποιηθούν την Κυριακή (2/10) στην Αθήνα λόγω της διεξαγωγής του 14ου Αγώνα δρόμου και Περιπάτου «Race for the Cure».
Αναλυτικά οι κυκλοφοριακές ρυθμίσεις:
Σταδιακή διακοπή της κυκλοφορίας των οχημάτων, κατά τις ώρες 07.00΄ έως 13.00΄, ως εξής:
Λ. Βασ. Αμαλίας, σε όλο το μήκος της και στα δύο (2) ρεύματα κυκλοφορίας και στις καθέτους αυτής μέχρι την πρώτη παράλληλη οδό.